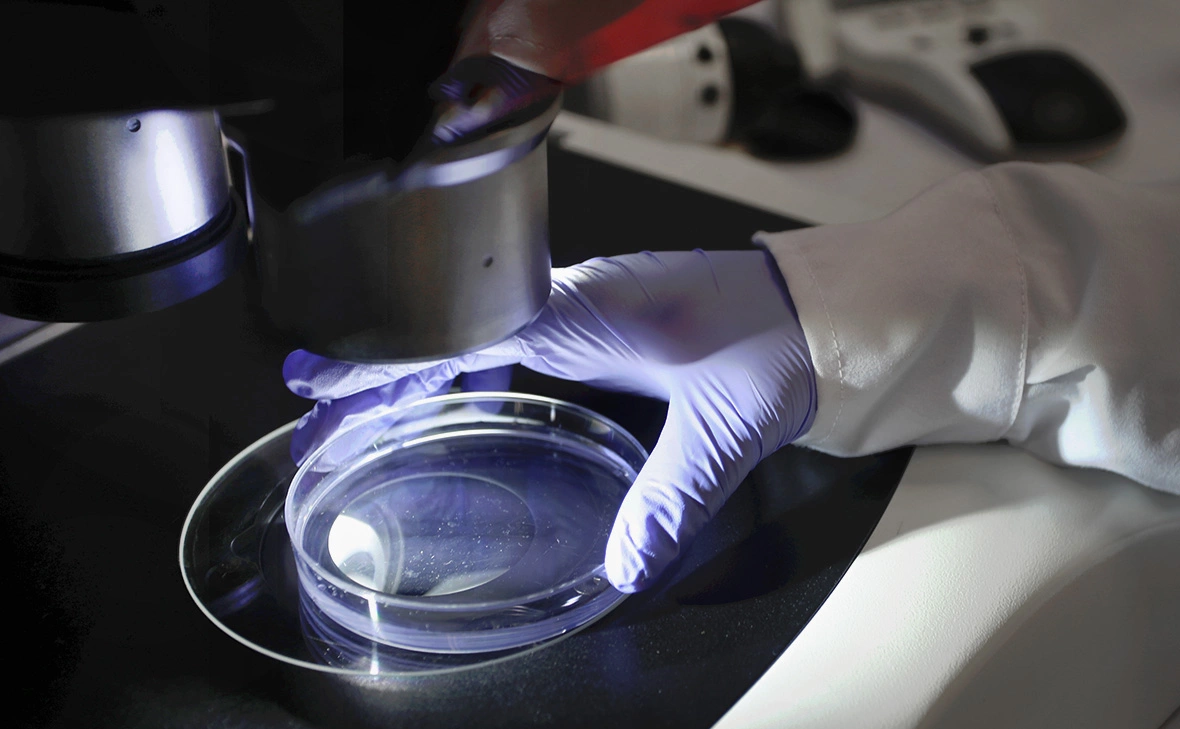
Raul Sifuentes / Getty Images

Ученые сочли излишним оптимизм по поводу «исчезновения» штамма гриппа
Вирусолог Вознесенский: штамм гриппа В мог пропасть из-за мер против COVID
То, что вирус гриппа B «Ямагата» почти не встречается, не обязательно означает его окончательное исчезновение, считают вирусологи. На это могли повлиять меры против коронавируса, но этот штамм в целом менее заразен, чем тип А
Фото: Raul Sifuentes / Getty Images
То, что штамм вируса гриппа B/Yamagata («Ямагата») практически не встречается, может быть следствием антикоронавирусных мер, однако не исключено, что через какое-то время он вернется, заявили опрошенные РБК вирусологи. Так они прокомментировали выводы американских ученых, которые заявили, что штамм пропал после карантина и масочного режима во время пандемии.
«Говорить однозначно, что повторное введение таких карантинных мероприятий позволит нам полностью избавиться от вируса гриппа, на мой взгляд, крайне оптимистично. Поэтому какие-то определенные изменчивости линии B мы можем приписать тем ковидным ограничениям, которые были, но прогнозировать, что повторно такой глобальный карантин поможет нам справиться с другими вирусами гриппа, — точно нет. Единственным эффективным способом борьбы с гриппом на сегодняшний день остается ежегодная вакцинация обновленными вакцинами», — заявил РБК доцент кафедры инфекционных болезней РУДН Сергей Вознесенский.
Вознесенский отметил, что сам по себе вирус гриппа В менее заразен и не вызывает эпидемий, а чаще всего распространяется локальными вспышками. Не несет он и такого количества летальных исходов, пояснил он.
Руководитель лаборатории особо опасных инфекций Федерального исследовательского центра фундаментальной и трансляционной медицины (ФИЦ ФТМ) Александр Чепурнов также считает, что нет полной уверенности в окончательном исчезновении «Ямагаты».
«Возможно, что вирус где-то в человеческой популяции сохранился, и тогда через какое-то время он восстановится, снова придет. Для того чтобы такой возбудитель исчез, необходимо, чтобы в какую-то единицу времени достаточно продолжительную, месяц например, чтобы не болел ни один человек, чтобы прервать передачу. Такое возможно для возбудителей, которые являются строгими антропонозами, связаны только с человеком, и у них нет никакой способности паразитировать на других животных», — отметил Чепурнов. Вирусолог напомнил, что это удалось сделать с вирусом натуральной оспы.
Ранее ученые Национального центра биотехнологической информации США (NCBI) пришли к выводу, что самоизоляция, ношение масок и другие меры, направленные на сдерживание распространения COVID-19, привели к исчезновению штамма вируса гриппа В «Ямагата». В исследовании говорится, что на протяжении последних десятилетий эпидемии гриппа вызывались четырьмя основными штаммами, в том числе «Ямагата», но теперь же ученые выявляют только три из них.
Теперь специалисты считают, что таким же образом можно избавиться от другого более распространенного штамма гриппа типа B — «Виктория». Однако в среднем на штаммы этого типа приходится 23% ежегодных случаев гриппа во всем мире, включая 1,4 млн госпитализаций.










